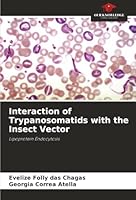
Interaction of Trypanosomatids with the Insect Vector 6202370394 Book Cover
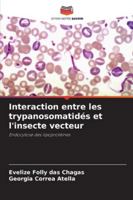
Interaction entre les trypanosomatidés et l'insecte vecteur (French Edition) 620237036X Book Cover

Most Popular Books
- Interaction of Trypanosomatids with the Insect Vector
- Interazione dei tripanosomatidi con l'insetto vettore (Italian Edition)
- Interaktion von Trypanosomiden mit dem Insektenvektor (German Edition)
- Interaction entre les trypanosomatidés et l'insecte vecteur (French Edition)
- Interakcja trypanosomów z owadem bedacym wektorem (Polish Edition)